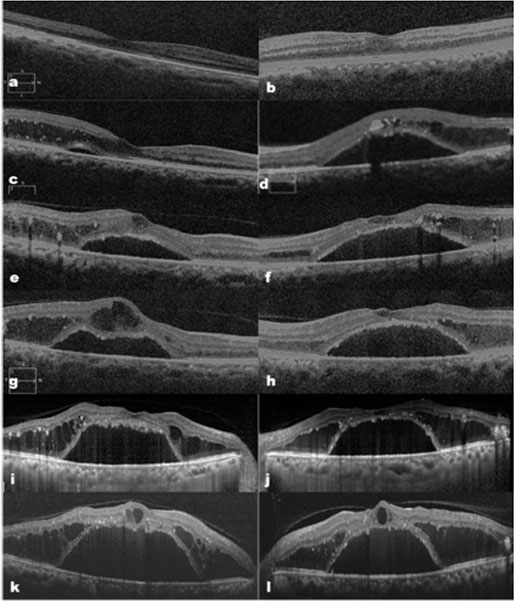

Dr. Ashish Khodifad, K18553, Dr.Nagesha
Introduction:
Paraproteinemia is the presence of excess amount of single monoclonal gamma globulin in the body. Thisresults secondary to multiple myeloma, immunocytoma or Waldenstrom macroglobulinemia.1They are characterized by signs and symptoms of hyper viscosity and hemorrhagic tendency. Ocular manifestations have been described which are characterized by retinal venous occlusions, optic disc swelling, and rarely serous macular detachments.2-5 In the absence of systemic symptoms, ocular manifestations alone may pose diagnostic and therapeutic challenge. Moreover in the setting of background diabetic retinopathy, signs of fundus changes of paraproteinemia are overlooked and managed in the line of standard diabetic retinopathy treatment.
In such situations, unresponsive cases need prompt further evaluation to rule out co-morbid conditions which not only unearth serious underlying secondary conditions but also help in correct management of such cases.Here, we have encountered similar cases of serous maculopathy masquerading as nonresponsive diabetic macular edema in otherwisesystemically asymptomatic patients. Presence of paraproteinemia was discovered in all these cases on the basis of systemic evaluation prompted by loss of vision and nonresponse to standard treatment.
Case 1
A 47 year old man with a medical history of diabetes mellitus and moderate non proliferative diabetic retinopathy (NPDR) was on regular follow up since 5 years. Best corrected visual acuity (BCVA) was 20/20 in both eyes and retinopathy appeared stable at all the visits and same is his glycemic control (HbA1c Range 5-6). Recently, he walked into clinic with recent complaint of defective vision in left eye. BCVA was 20/20P in right eye and 20/30 in left eye. Dilated fundus examination showed features of moderate NPDR and macula showed near circular 2-3 disc diameter size neurosensory detachment with yellowish precipitates underneath (Picture1a,b). The venules appeared slightly wider with AV ratio of 1:4. Optical Coherence Tomography (OCT) scan through macula showed foveal detachment with intraretinal cystoid edema in the parafoveal region (Picture1c, d). Fundus fluorescein angiography(FFA) showed no significant leakage which could account for the macular changes.
In the background of diabetic retinopathy, diagnosis of centre-involving macular edema was made and intravitreal antiVEGF was tried. Multiple antiVEGF injections followed by trial of intravitreal steroids failed to resolve the macular edema. His visual acuity dropped to 20/40P in right eye and 20/60 in left eye.
Throughout the follow-up visits, patient’s history was unremarkable except for blurred vision. He denied any systemic illness other than diabetes. Slight engorged venules and progressive worsening of foveal detachments (picture-2) prompted us to investigate for hyper viscosity conditions. Serum electrophoresis showed presence of M band and bone marrow aspiration showed 30% marrow cellularity with predominantly mature and few immature plasma cells; suggestive of multiple myeloma. Patient was referred to hematologist for further systemic evaluation. He later was started with Immunosuppressive therapy (Tab Rituximab) and subsequent follow-ups showed resolution of hyperviscosity and stabilization of maculopathy.
Case 2
A 63 year old man with a medical history of diabetes mellitus for 20 years presented with complaint of defective vision in left eye since 5 months. BCVA was 20/30P in right eye and 20/120 in left eye. Slit lamp evaluation showed lens changes in both eyes. Dilated fundus examination of right eye showed few dot blot hemorrhages and dull foveal reflex. Left eye showed dot blot hemorrhages in 2-3 quadrants and the macula showed 2-3 disc diameter size neurosensory detachment with subretinal yellowish precipitates.
FFA showed moderate NPDR changes with nosignificant leakage at macula.OCT scan through macula showed foveal detachment in left eye and small pocket of subretinal fluid in right eye. Patient was treated as center involving macular edema. Macular changes remained unchanged after 2 monthly injections of AntiVEGF.
On follow up, retinal veins appeared more dilated in both eyes without tortuosity or increase in hemorrhages.Hyperviscosity syndrome was suspected and was subjected tofurther systemic work-up. Serum immunoglobulin IgM was >5000µg/dl and electrophoresis showed presence of ‘M’ band. Diagnosis of Waldenstrom macroglobulinemia was made and started on systemic Brotezomib followed by Rituximab. On subsequent visit, right eye showed resolution of macular edema and left eye showed slight decrease in height of foveal detachment.
Case-3:
A 48-year-old female with 15 years of diabetes history presented with complaints of blurred vision in both eyes since last 1 month. She had history of weight loss of more than 20kg in the last 1 year.She has taken treatment for kidney stones. The BCVA was 20/60 in both eyes and anterior segment of the right eye showed few pigments on lens capsule suggestive of old anterior uveitis. Fundus examination showed background diabetic retinopathy with peripapillary retinal edema and serous detachment at macula. (Picture 4)
Further systemic evaluation was carried out as the maculopathy did not respond to multiple intravitreal avastin and steroids. Blood examination revealed anemia of 9.2mg%, and serum protein estimation revealed abnormal globulin levels and electrophoresis confirmed presence of M band. A diagnosis of Waldenstrom macroglobulinemiawas made and referred to oncologist for further evaluation and management
Discussion
Serum hyperviscosity is the etiologic factor in several ophthalmic disorders, many of which may have similar retinal findings. The above 3 cases present significant diagnostic and therapeutic challenge. Here, patients with history of background diabetic retinopathy would lead examiner to probable diagnosis of diabetic macular edema. In the absence of other associated fundus features as in case 1 along with denial of any systemic symptoms delayed early recognition of paraproteinemic maculopathy.
In the second case, the engorged veins developed 4-5 months after development of maculopathy which otherwise mimicked diabetic macular edema, especially in left eye. The serous detachments in these cases are thought to be exudative in nature; and found to have IgM in subretinal space suggesting that an increased osmotic gradient causes fluid accumulation under the retina.6 Ashton and Foos et al7 observed that hyperviscosity can cause stasis and hypoxia leading to endothelial decompensation. This causes secondary breakdown of blood retinal barrier in addition to RPE decompensation. Coexisting diabetic retinopathy exacerbates the severity posing additional risk factor enhancing leakage and so the poor treatment response.
Wide spectrum of ocular manifestations has been described in diagnosed case of gammaglobulinopathy. They include venous stasis retinopathy,immunoprotein deposition in the cornea, IgM deposits in retinal layers and serous macular detachment. All these are secondary to serum hyperviscosity and clinical recognition of these findings is early when the systemic history is known. On the other hand, diabetic retinopathy secondary to poorly controlled diabetes can present with engorged veins,retinal hemorrhages, venous occlusion and also serous macular detachment. The overlap of fundus findingsmay delay the recognition of early fundus features of paraproteinemias.
Angiographically silent macular detachment is the hallmark of immunogammapathy associated macular detachment.8 On the other hand, differentials like central serous chorioretinopathy, hypertensive retinopathy, inflammatory choroidopathy like lupus and infiltrative lesions like lymphoma invariably present with some angiographic leakage at the level of RPE and/or retinal vasculature. In all the above cases, FFA showed minimal leakage which could not be accountable for amount of macular edema and foveal detachment which could clue us to investigate for exudative conditions.
The paraproteinemic maculopathy becomes symptomatic when IgM level exceeds 4000 mg/dl in diabetics and 7000 mg/dl in non-diabetics and serum viscosity exceeds 5.5cP.9This is the probable reason that ocular manifestations preceded the systemic symptoms in our patient who was a known diabetic for more than 5 years. Early recognition of this entity and prompt referral to hematologist is necessary for systemic monitoring and treatment. Immunosuppressives and/or plasmapheresis are indicated in cases of maculopathy secondary to hyperviscosity. In present case series, chemotherapy resulted in slight decrease in macular edema though visual acuity remained the same. Various intravitreal injections9failed to show a definitive benefit in such cases as mirrored in our cases. Majority of cases will have persistent subretinal fluid despite improvement of systemic hyperviscosity and so bad visual prognosis.
To conclude, diagnosis of paraproteinemic maculopathy mimicking as recalcitrant diabetic macular edema in otherwise systemically asymptomatic patients poses a diagnostic challenge. Though rare, prompt recognition of this entity amidst plethora of differentials is very important as underlying conditions carry high risk of morbidity and mortality. A thorough evaluation by a hematologist or an oncologist should be carried for early recognition and prompt treatment.
References
- Natvig JB, Kunkel HG: Human immunoglobulins. Classes, subclasses, genetic variants and idiotypes. Adv Immunol x:1-59. 1973.
- Orellana J, Friedman AH. Ocular manifestations of multiple myeloma, Waldenstrom’s macroglobulinemia and benign monoclonal gammopathy. Surv Ophthalmol 1981;26:157–69.
- Carr RE, Henkind P. Retinal findings associated with serum hyperviscosity. Am J Ophthalmol 1963;56:23–31.
- Franklin RM, Kenyon KR, Green WR, et al. Epibulbar IgA plasmacytoma occuring in multiple myeloma [case report]. Arch Ophthalmol 1982;100:451–6.
- Pilon AF, Rhee PS, Messner LV. Bilateral, persistent serous macular detachments with Waldenstrom’s macroglobulinemia. Optom Vis Sci 2005;82(7):573–578.
- Khouri GG, Murphy RP, Kuhajda FP, Green WR. Clinicopathologic features in two cases of multiple myeloma. Retina 1986;6:169–75.
- Ashton N. Ocular changes in multiple myelomatosis. Arch Ophthalmol 1965;73:487–94.
- Ho AC, Benson WE, Wong J. Unusual immunogammopathy maculopathy. Ophthalmology. 2000 Jun;107(6):1099-103.
- Mansour AM, Arevalo JF, Badal J, Moorthy RS, Shah GK, Zegarra H, Pulido JS, Charbaji A, Amselem L, Lavaque AJ, Casella A, Ahmad B, Paschall JG, Caimi A, Staurenghi G. Paraproteinemic maculopathy. Ophthalmology. 2014 Oct;121(10):1925-32
Pictures:

Picture 1: Case-1, showing background diabetic retinopathy with bilateral serous detachment (arrow heads) of the macula (a, b). Corresponding OCT picture showing large foveal detachment with surrounding outer retinal cystoid edema (c, d). (Insets show level of macular scans).
Picture 2: Case-1 with series of OCT scans (c-i) through macula over 12 months showing progressive increase in foveal detachment and outer retinal cystoid separations. (a, b are scans 2 years before the onset of symptoms showing near normal macular configuration)

Picture 3: case-2fundus showing appearance of engorged retinal venules (arrows) in both eyes over background diabetic retinopathy changes (a, b). OCT pictures (c, d) showing asymmetrical foveal detachment with intraretinal cystoid edema which received multiple anti-VEGF injections. (Insets show level of macular scans).

Picture 4: case-3 fundus shows backgrounddiabetic retinopathy with central serous detachment of macula (a, b). Corresponding OCT pictures confirming serous detachment with intraretinal cystic changes (c, d). (Insets show level of macular scans).



Leave a Comment